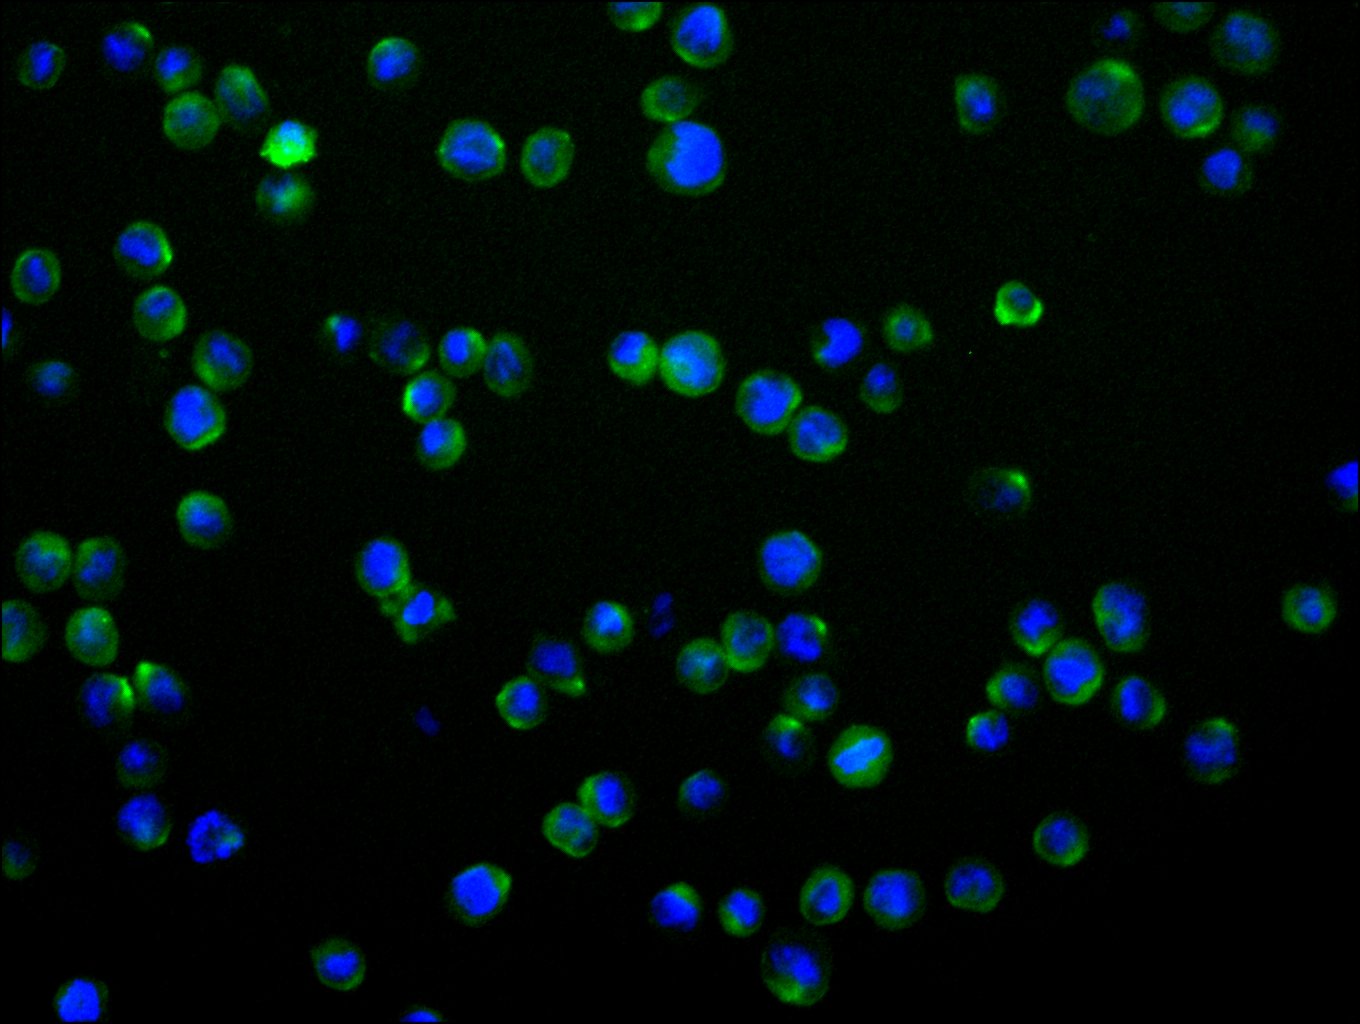

TNFRSF1B Recombinant Monoclonal Antibody
-
中文名稱:TNFRSF1B Recombinant Monoclonal Antibody
-
貨號:CSB-RA159920A0HU
-
規格:¥1320
-
圖片:
-
Western Blot
Positive WB detected in: HeLa whole cell lysate(30μg), HepG2 whole cell lysate(30μg), PC-3 whole cell lysate(30μg), MCF-7 whole cell lysate(30μg), K562 whole cell lysate(30μg), COLO205 whole cell lysate(30μg), HEK293T whole cell lysate(30μg)
All lanes: TNFRSF1B antibody at 1:1000
Secondary
Goat polyclonal to rabbit IgG at 1/50000 dilution
Predicted band size: 48 kDa
Observed band size: 48 kDa
Exposure time: 2min -
Immunofluorescence staining of THP-1 cell with CSB-RA159920A0HU at 1:50, counter-stained with DAPI. The cells were fixed in 4% formaldehyde and blocked in 10% normal Goat Serum. The cells were then incubated with the antibody overnight at 4°C. The secondary antibody was Alexa Fluor 488-congugated AffiniPure Goat Anti-Rabbit IgG(H+L).
-
Overlay Peak curve showing HT29 cells stained with CSB-RA159920A0HU (red line) at 1:100. Then 10% normal goat serum to block non-specific protein-protein interactions followed by the antibody (1ug/1*106cells) for 45min at 4℃. The secondary antibody used was FITC-conjugated goat anti-rabbit IgG (H+L) at 1/200 dilution for 35min at 4℃.Control antibody (green line) was Rabbit IgG (1ug/1*106cells) used under the same conditions. Acquisition of >10,000 events was performed.
-
-
其他:
產品詳情
-
Uniprot No.:
-
基因名:
-
別名:CD120b antibody; p75 antibody; p75 TNF receptor antibody; p75TNFR antibody; p80 TNF alpha receptor antibody; p80 TNF-alpha receptor antibody; Soluble TNFR1B variant 1 antibody; TBP-2 antibody; TBPII antibody; TNF R II antibody; TNF R2 antibody; TNF R75 antibody; TNF-R2 antibody; TNF-RII antibody; TNFBR antibody; TNFR-II antibody; TNFR1B antibody; TNFR2 antibody; TNFR80 antibody; TNFRII antibody; Tnfrsf1b antibody; TNR1B_HUMAN antibody; Tumor necrosis factor beta receptor antibody; Tumor necrosis factor binding protein 2 antibody; Tumor necrosis factor receptor 2 antibody; Tumor necrosis factor receptor superfamily member 1B antibody; Tumor necrosis factor receptor type II antibody; Tumor necrosis factor-binding protein 2 antibody
-
反應種屬:Human
-
免疫原:A synthesized peptide derived from human TNFRSF1B
-
免疫原種屬:Homo sapiens (Human)
-
標記方式:Non-conjugated
-
克隆類型:Monoclonal
-
抗體亞型:Rabbit IgG
-
純化方式:Affinity-chromatography
-
克隆號:14C4
-
濃度:It differs from different batches. Please contact us to confirm it.
-
保存緩沖液:Rabbit IgG in 10mM phosphate buffered saline , pH 7.4, 150mM sodium chloride, 0.05% BSA, 0.02% sodium azide and 50% glycerol.
-
產品提供形式:Liquid
-
應用范圍:ELISA, WB, IF, FC
-
推薦稀釋比:
Application Recommended Dilution WB 1:500-1:2000 IF 1:50-1:200 FC 1:50-1:200 -
Protocols:
-
儲存條件:Upon receipt, store at -20°C or -80°C. Avoid repeated freeze.
-
貨期:Basically, we can dispatch the products out in 1-3 working days after receiving your orders. Delivery time maybe differs from different purchasing way or location, please kindly consult your local distributors for specific delivery time.
-
用途:For Research Use Only. Not for use in diagnostic or therapeutic procedures.
相關產品
靶點詳情
-
功能:Receptor with high affinity for TNFSF2/TNF-alpha and approximately 5-fold lower affinity for homotrimeric TNFSF1/lymphotoxin-alpha. The TRAF1/TRAF2 complex recruits the apoptotic suppressors BIRC2 and BIRC3 to TNFRSF1B/TNFR2. This receptor mediates most of the metabolic effects of TNF-alpha. Isoform 2 blocks TNF-alpha-induced apoptosis, which suggests that it regulates TNF-alpha function by antagonizing its biological activity.
-
基因功能參考文獻:
- TL1A modulated Rheumatoid arthritis-fibroblast-like synoviocytes migration and Indian hedgehog signaling pathway using TNFR2. PMID: 29748156
- Data suggest that maternal glycemic response during pregnancy is associated with lower DNA methylation of 4 CpG sites within PDE4B gene in placenta (collected after normal-weight term birth); 3 additional CpG sites are differentially methylated relative to maternal glucose response within TNFRSF1B, LDLR, and BLM genes. (PDE4B = phosphodiesterase-4B; LDLR = low density lipoprotein receptor; BLM = Bloom syndrome protein) PMID: 29752424
- serum level did not change after tonsillectomy alone but decreased significantly after steroid pulse therapy in patients with IgA nephropathy PMID: 28389814
- Elevated serum TNFR2 may be a possible marker of COPD in asymptomatic smokers and ex-smokers. PMID: 28744116
- TNFR2 promoted Adriamycin resistance in breast cancer cells by regulating the DNA damage repair. PMID: 28677724
- Serum TNFR2 is a biomarker for patients with chronic kidney disease. PMID: 28667032
- Data indicate activators of tumor necrosis factor receptor 2 (TNFR2) and a potential role for this target in immunotherapy. PMID: 27626702
- In this study, we identified a novel association between ANCA levels, TNFRSF1B genotype and decreased circulating TNFR2 levels, which may be reflective of the underlying biological mechanisms that determine clinical expression and/or response to certain therapies. PMID: 27104820
- In Han Chinese population of Hunan province, TNFRSF1B+676 gene polymorphisms are not associated with the genetic risk of rheumatoid arthritis PMID: 27640805
- Results showed that TNFR2 was upregulated in papillary thyroid carcinoma tissues, and its expression is regulated by H19. PMID: 29287713
- The TNFRSF1Brs3397 variant may play a role in modulating the risk of rheumatoid arthritis, but does not provide strong evidence of an impact of TNFRSF1B variants in determining response to anti-TNF drugs. PMID: 25850964
- atopic dermatits patients had increased TNFR2 expression on immune cells PMID: 29212072
- the blocking of tumor necrosis factor receptor 2 (TNFR2) decreased TL1A-stimulated IL-6 production by rheumatoid arthritis fibroblast-like synoviocytes. PMID: 27081759
- Data suggest that, by targeting tumor cells and immunosuppressive tumor-associated Tregs, antagonistic tumor necrosis factor receptor 2 (TNFR2) antibodies may be an effective treatment for cancers positive for TNFR2. PMID: 28096513
- p75 neurotrophin receptor (p75TNFR) was the first NGFR (nerve growth factor receptor) to be cloned and the founding member of the TNFR (tumor necrosis factor receptor) superfamily. However, data suggest that p75TNF is an atypical TNFR superfamily protein; p75TNFR forms dimers (activated by dimeric neurotrophins) that are structurally unrelated to TNFR superfamily proteins. [REVIEW] PMID: 28215307
- High plasma levels of TNFR2 and TNFR1 were associated with incident intracerebral hemorrhage. PMID: 28830973
- Serum TNFR2 levels were elevated in lupus nephritis patients versus controls. PMID: 27973968
- Voxel-based morphometry was used to analyse the associations between TNFRSF1B (rs1061624) genotypes and grey matter structure. Analysis of the TNFRSF1B SNP rs1061624 yielded a significant association with hippocampal but not with striatal volume, whereby G homozygotes were associated with increased volumes relative to A homozygotes and heterozygotes. PMID: 27528091
- Our results demonstrated that Treg frequencies and TNFR2 expression on Tregs are increased in sarcoidosis, followed by a decline during infliximab therapy, suggesting a pathophysiological role of this T cell subset. PMID: 27158798
- identified 6 known and 4 novel variations in 6 different exons of TNFR2 gene; out of these identified variations, 5 known variations were found to be significantly associated with the risk of cervical cancer; postmenopausal women having CAAGC + CTGCC haplotypes in TNFR2 gene along with HPV infection and tobacco consumption may lead to the development of cervical cancer PMID: 27145290
- LTbetaR is essential for efficient liver regeneration and cooperates with TNFRp55 in this process. Differences in survival kinetics strongly suggest distinct functions for these two cytokine receptors in liver regeneration. PMID: 26708145
- that U87-p75(NTR) cells express higher levels of Cdh-11 protein and that siRNA-mediated knockdown of Cdh-11 resulted in a significant decrease in p75(NTR)-mediated glioblastoma cell migration PMID: 26476273
- TNF-alpha/TNFR2 regulatory axis stimulates EphB2-mediated neuroregeneration via activation of NF-kappaB. PMID: 26492598
- This meta-analysis demonstrates that TNFRSF1B T allele carriers show a better response to anti-TNF therapy--{REVIEW} PMID: 26071216
- Pretransplant recipient circulating CD4+CD127lo/-TNFR2+ Treg cell is potentially a simpler alternative to Treg cell function as a pretransplant recipient immune marker for acute kidney injury. PMID: 26425877
- NGF has a role in modulating trkANGFR/p75NTR in alphaSMA-expressing conjunctival fibroblasts from human ocular cicatricial pemphigoid PMID: 26569118
- our findings implicate TNFR2 in supporting myeloid-derived suppressor cells -mediated immune suppression and metastasis in the liver PMID: 26483205
- In conclusion, we report a significant association between the TNFRSF1B p.M196R variant and the risk for psoriasis and the response to treatment with anti-TNF or anti-Il-12/Il-23. PMID: 25537528
- Plasma sTNFR2 was higher during pregnancy compared with controls. Urinary levels of sTNFR2 were higher in preeclampsia and pregnant women compared with controls. PMID: 25034210
- study suggests that TNFR2(+) Tregs play a role in promoting tumor progressive metastasis PMID: 26280204
- Recurrent point mutations and genomic gains of TNFRSF1B, encoding the tumor necrosis factor receptor TNFR2, are present in a subset of patients with mycosis fungoides and Sezary syndrome. PMID: 26258847
- Increased plasma level of sTNFRII is found to be associated with exudative age-related macular degeneration. PMID: 25363549
- ADAM17 was identified as the protease responsible for TNFR2 shedding by CD8(+) T cells, with ADAM17 and TNFR2 required in "cis" for shedding to occur. PMID: 26019295
- hTNFR2 blocks the biological activity of lymphotoxin beta. PMID: 25940088
- NRH2 enhanced the ratio of Bax/Bcl-2 by promoting the expressions of proNGF, sortilin and p75NTR, thereby inducing brain cell apoptosis. PMID: 25854576
- Only TNFR2 can induce TRAF2 degradation. PMID: 25152365
- Data show that TNF-alpha receptor TNFR2 mRNA expression was significantly increased after 6, 9 and 12 hours of poly (I:C) stimulation. PMID: 25419735
- Functional TNFR2 196 M/R polymorphism is associated with susceptibility to rheumatoid arthritis in the European population. PMID: 24777778
- Serum TNFR2 is associated with renal decline and ESRD risk in type 1 diabetes and proteinuria. PMID: 24898299
- The TNFRII nt587 G/G genotype may increase the risk of developing AS in the Chinese population. PMID: 25061744
- High TNF receptor 2 is closely associated with the loss of kidney function. PMID: 24717758
- Inflammation mediated through TNFalpha and its receptors, TNFR1 and TNFR2, may represent an important component of a comorbidity-induced inflammatory response that partially drives the pathophysiology of heart failure (HF) with preserved ejection fraction. PMID: 24923671
- TNF-TNFR2 signaling may induce RBR in naive BM-EPCs and that blocking TNF-TNFR2 signaling may prevent delayed RBR in BM-EPCs, conceivably, in bone marrow milieu in general PMID: 24711449
- Blood levels of CRP, IL-6 and TNFalpha-R2 are not associated with incident depression. PMID: 24836084
- Addition of leukemia inhibitory factor (LIF) neutralizing antibodies inhibited oligodendrocyte differentiation, indicating a crucial role of TNFR2-induced astrocyte derived LIF for oligodendrocyte maturation PMID: 24310780
- Higher plasma TNFR75 levels were associated with decreased time to first COPD exacerbatino in a prospective study. PMID: 24136332
- Our results support a role of TNFRSF1B gene variants in the response to IFX in CD patients. PMID: 24121042
- Serum TNFR2 expression levels might be a powerful prognostic factor for patients treated with the R-CHOP regimen. PMID: 23672298
- Release of nonmuscle myosin II from the cytosolic domain of tumor necrosis factor receptor 2 is required for target gene expression. PMID: 23861542
- genetic association studies in a population of women in Tunisia: Data suggest that an SNP in exon 6 of TNFR2/TNFRSF1B (rs1061622) is associated with pre-eclampsia. PMID: 23799986
顯示更多
收起更多
-
亞細胞定位:[Isoform 1]: Cell membrane; Single-pass type I membrane protein.; [Isoform 2]: Secreted.; [Tumor necrosis factor-binding protein 2]: Secreted.
-
數據庫鏈接:
Most popular with customers
-
-
YWHAB Recombinant Monoclonal Antibody
Applications: ELISA, WB, IHC, IF, FC
Species Reactivity: Human, Mouse, Rat
-
Phospho-YAP1 (S127) Recombinant Monoclonal Antibody
Applications: ELISA, WB, IHC
Species Reactivity: Human
-
-
-
-
-